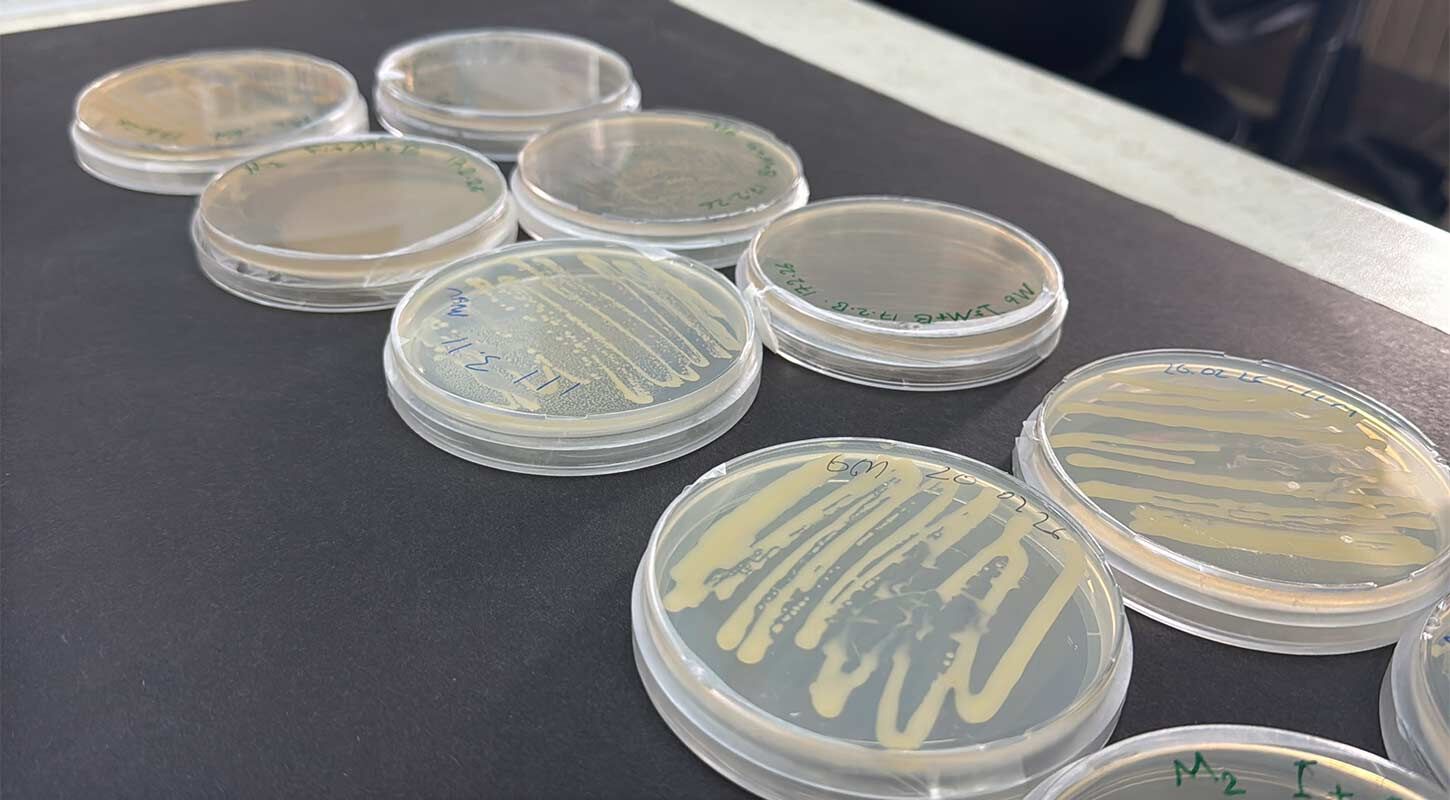
Omu Antartika 3

Samsun’daki Ondokuz Mayıs Üniversitesi (OMÜ), Antarktika’dan getirilen mikroorganizmaları tarıma kazandırmak için kapsamlı bir araştırma başlattı. TÜBİTAK destekli proje kapsamında bilim insanları, kutuplardan alınan bakterilerin kimyasal gübrelere alternatif olup olamayacağını araştıracak.
Projenin koordinatörlüğünü OMÜ Ziraat Fakültesi Tarımsal Biyoteknoloji Bölümü’nden Dr. Öğr. Üyesi Yılmaz Kaya yürütüyor. Araştırma ekibinde Dr. Öğr. Üyesi Ayşe Feyza Tufan Dülger ve Prof. Dr. Hasan Murat Aksoy da yer alıyor. Çalışmaya ayrıca Marmara Üniversitesi ve Malezya Teknoloji Üniversitesi’nden akademisyenler de katkı sunuyor.

Antarktika: Doğal Bir Laboratuvar
Dr. Yılmaz Kaya, Antarktika’nın eşsiz bir ekosistem olduğunu belirterek, bölgenin adeta “doğal bir laboratuvar” niteliği taşıdığını söyledi.
Proje kapsamında Antarktika’dan alınan mikroorganizma örnekleri OMÜ laboratuvarlarında izole edilecek, ardından moleküler düzeyde tanımlanacak. Sonraki aşamada bu bakterilerin tarımsal biyoteknolojide kullanılıp kullanılamayacağı test edilecek.

Bilim insanları özellikle şu sorulara yanıt arayacak:
-
Soğuk iklim koşullarında aktif kalabilir mi?
-
Azot ve fosfor fiksasyonu yapabilir mi?
-
Kimyasal gübrelere alternatif olabilir mi?
Kimyasal Gübreye Alternatif mi Geliyor?
Modern tarımda yoğun şekilde kullanılan kimyasal gübrelerin çevresel ve toprak sağlığı açısından bazı olumsuz etkileri bulunuyor. OMÜ’lü araştırmacılar, Antarktika’dan izole edilen bakterilerin bu kimyasal girdilere alternatif oluşturup oluşturamayacağını araştıracak.
İzole edilen bakteriler, OMÜ Ziraat Fakültesi Tarımsal Biyoteknoloji Laboratuvarı’nda moleküler karakterizasyon sürecinden geçirilecek. Bitki Koruma Bölümü’nde ise bu mikroorganizmaların bitkiler üzerinde patojen etkisi olup olmadığı test edilecek.
Biyokontrol Ajanı Olarak Kullanılabilir mi?
Projede bir diğer önemli aşama ise biyokontrol potansiyeli. Eğer bakterilerin patojen olmadığı tespit edilirse, bu mikroorganizmaların zararlı mantar ve hastalıklara karşı biyolojik mücadelede kullanılıp kullanılamayacağı değerlendirilecek.
Özellikle fusaryum gibi önemli bitki patojenlerine karşı antagonistik etkileri araştırılacak. Ayrıca genom düzeyinde analizler yapılacak ve bu çalışmalar Malezya Teknoloji Üniversitesi’nde sürdürülecek.

Bitki Gelişimini Destekleyen Bakteriler
Prof. Dr. Hasan Murat Aksoy ise faydalı bakterilerin topraktaki besin elementlerini bitkilerin alabileceği forma dönüştürdüğünü belirtti. Bu özellikleri sayesinde hem bitki gelişimini teşvik edebilecekleri hem de biyolojik mücadele ajanı olarak kullanılabilecekleri ifade edildi.
Elde edilecek sonuçlar, özellikle soğuk iklim bitkilerinde sürdürülebilir tarım açısından önemli bir adım olabilir.




